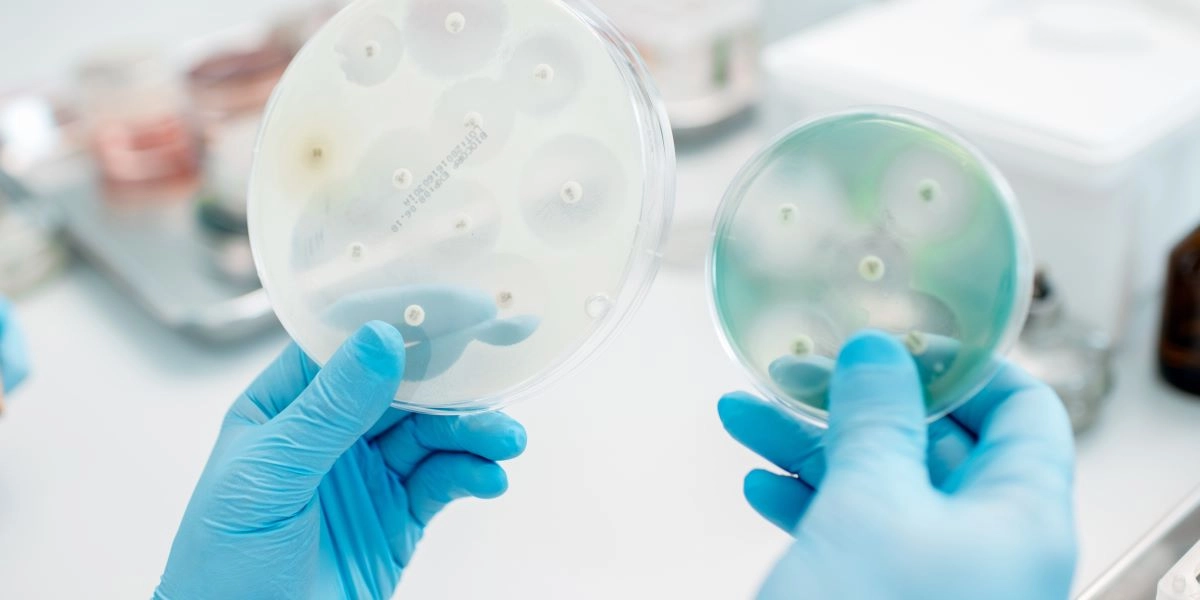
Εξέταση βακτηρίων

Η φαρμακευτική εταιρεία της Δανίας Bavarian Nordic, που παρασκευάζει το εμβόλιο για την mpox, ανακοίνωσε σήμερα ότι ζήτησε από τον Ευρωπαϊκό Οργανισμό Φαρμάκων την επέκταση της χρήσης του σκευάσματος και στους νέους 12-17 ετών.
Η εταιρεία ανακοίνωσε ότι τα ενδιάμεσα αποτελέσματα κλινικής έρευνας δείχνουν ότι η ανοσολογική απόκριση του εμβολιασμού κατά της mpox και της ευλογιάς στους εφήβους και το προφίλ ασφάλειας του σκευάσματος είναι αντίστοιχα με τα αποτελέσματα του εμβολιασμού στην κατηγορία των ενηλίκων.
Στις Ηνωμένες Πολιτείες, κατά την διάρκεια της προηγούμενης επιδημίας της mpox το 2022, ο Οργανισμός Τροφίμων και Φαρμάκων (FDA) είχε δώσει άδεια επείγουσας χρήσης του εμβολίου για τους εφήβους.
Σήμερα, η ταχεία εξάπλωση της νόσου στην Αφρική οφείλεται κυρίως σε ένα νέο στέλεχος, το 1 (1b), που είναι περισσότερο μεταδοτικό και επικίνδυνο σε σχέση με τα προηγούμενα.
Η νόσος μεταδίδεται εν μέρει μέσω των σεξουαλικών επαφών, αλλά και μέσω μη σεξουαλικών επαφών απειλώντας έτσι τα παιδιά στα οποία η ασθένεια είναι περισσότερο επικίνδυνη.
Χθες, η Bavarian Nordic δήλωσε έτοιμη για την παραγωγή μέχρι 10 εκατομμυρίων δόσεων εμβολίων μέχρι το 2025.
Σήμερα η εταιρεία διαθέτει σε στοκ 500.000 δόσεις του εμβολίου.
Χθες, το πρώτο κρούσμα του στελέχους 1 εντοπίσθηκε στην Σουηδία, για πρώτη φορά εκτός της αφρικανικής ηπείρου.
Ο Παγκόσμιος Οργανισμός Υγείας προειδοποίησε ότι και άλλα κρούσματα της mpox θα εντοπισθούν προσεχώς στην Ευρώπη.
Ο ΠΟΥ κήρυξε το υψηλότερο επίπεδο συναγερμού σε παγκόσμιο επίπεδο απέναντι στον πολλαπλασιασμό των κρουσμάτων στην αφρικανική ήπειρο.
Το Πακιστάν ανακοίνωσε σήμερα τον εντοπισμό του πρώτου κρούσματος της mpox στο έδαφός του.